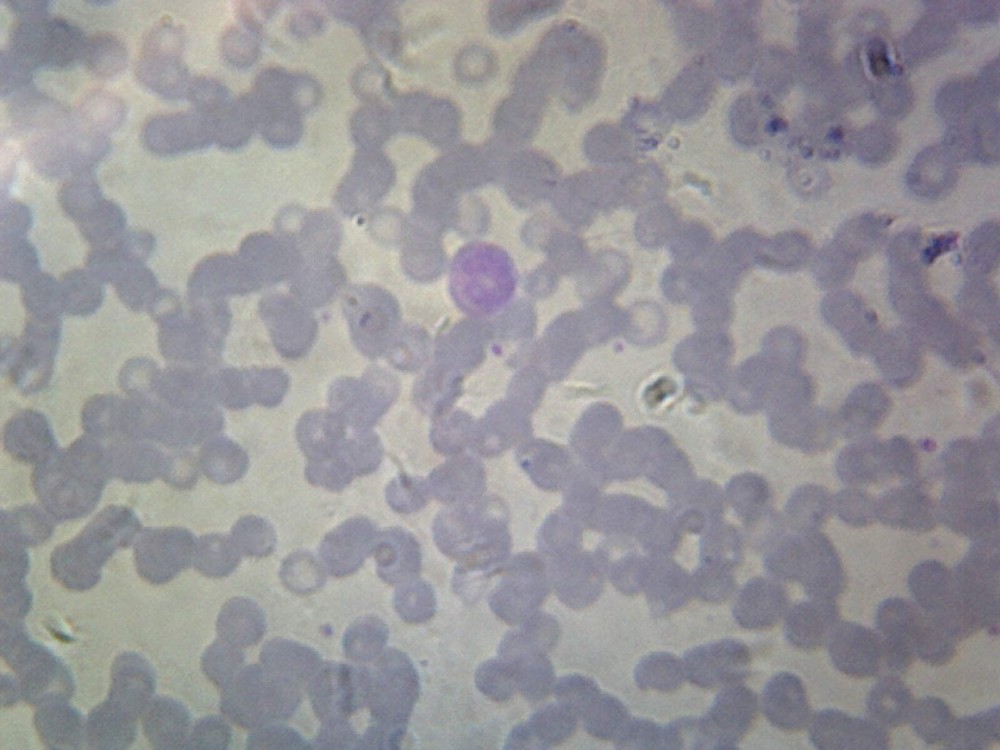
Balantidium Coli Trophozoites; Smear

| Brand | GSC International |
|---|---|
| Slide Material | Glass |
| Color | Clear |
| Intended Use/Discipline | Science Education Lab |
| Model | PS0019 |
| MPN | PS0019 |
| Country of Origin | China |
| Unit Quantity | 1 |
| Unit Type | Each |
| UPC | 762047810522 |
Check the listing for details. Pumpkin (Cucurbita) Stem; Longitudinal Section. Color: Clear, Condition: New, Made in China. Listed at 7.90 USD. Botany is the study of plants, including their structure, physiology, genetics, ecology, classification, and economic importance. This prepared microscope slide features a longitudinal section of a pumpkin (Cucurbita) stem.